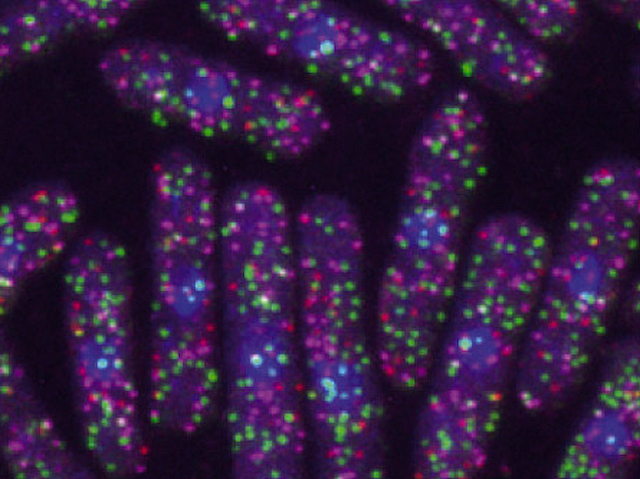

How cell size is controlled
29 April 2020
Scale Me Up
The cells in our body grow to become many different sizes, despite larger cells not having any extra copies of the genetic instructions needed to make cellular building blocks. Scientists investigated how cells scale-up production of these protein ‘blocks’ by studying fast growing yeast cells (lozenge shapes pictured). They used high-powered microscopes to track the yeast’s growth in real-time, and to explore whether changes in cell size are linked to the number of key molecules, which they labelled with fluorescence. The molecules of interest act as messengers, relaying information between the cell’s centre (nucleus), where it stores its DNA, and the “factories” that produce proteins. This relay process is critical because the DNA code, which acts as a blue-print for protein production, is vulnerable to damage, so cannot leave the nucleus. The number of messenger molecules, called RNA, was shown to increase in line with cell size and to underpin scaling.
Read more about this research from the Quantitative Gene Expression group at the MRC LMS here
Written by

- Image from work by Xi-Ming Sun and Anthony Bowman, and colleagues, Quantitative Gene Expression group, MRC LMS
- MRC London Institute of Medical Sciences, Imperial College London, London, UK
- Image originally published with a Creative Commons Attribution 4.0 International (CC BY 4.0)
- Published in Current Biology, February 2020
Search The Archive
Submit An Image
Like us on Facebook
Follow on Twitter
Follow on Tumblr
Follow on Instagram
What is BPoD?
BPoD stands for Biomedical Picture of the Day. Managed by the MRC Laboratory of Medical Sciences until Jul 2023, it is now run independently by a dedicated team of scientists and writers. The website aims to engage everyone, young and old, in the wonders of biology, and its influence on medicine. The ever-growing archive of more than 4000 research images documents over a decade of progress. Explore the collection and see what you discover. Images are kindly provided for inclusion on this website through the generosity of scientists across the globe.
BPoD is also available in Catalan at www.bpod.cat with translations by the University of Valencia.








